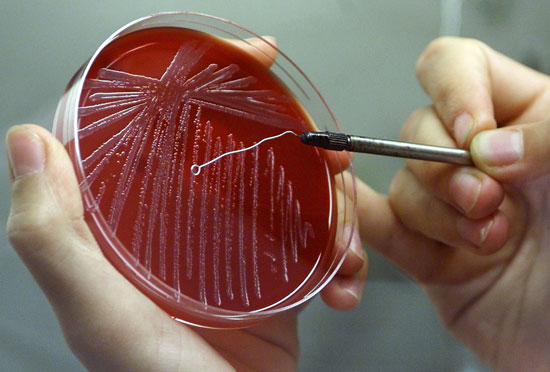

Les armes biologiques du Pentagone (2)
Lisez la première partie de cet article

Opération Bellwether
L’« US Army Chemical Research and Development Command, Biological Weapons Branch », a étudié l’activité de piqûre de moustiques en plein air lors d’un certain nombre d’essais sur le terrain à « Dugway Proving Ground », Utah, en 1960. Les moustiques femelles vierges Aedes aegypti, qui avaient été affamés, ont été testés sur des troupes en plein air.
Expériences militaires avec des moustiques et des tiques tropicaux en Géorgie
De telles espèces de moustiques et de puces (étudiées dans le passé dans le cadre du programme américain « Entomological Warfare Program ») ont également été collectées en Géorgie et testées au « Lugar Center ». Dans le cadre du projet DTRA « Virus et autres arbovirus en Géorgie » en 2014, le moustique tropical Aedes albopictus, jamais vu auparavant, a été détecté pour la première fois et après des décennies (60 ans), l’existence du moustique Aedes Aegypti a été confirmée en Géorgie occidentale.
Aedes Albopictus est un vecteur de nombreux pathogènes viraux, virus de la fièvre jaune, Dengue, Chikungunya et Zika. Ces moustiques tropicaux Aedes Albopictus n’ayant jamais été vus auparavant en Géorgie, ont également été détectés en Russie voisine (Krasnodar) et en Turquie. Selon les données fournies par le « Centre européen de prévention et de contrôle des maladies », leur propagation est inhabituelle pour cette partie du monde.
Les moustiques Aedes Aegypti n’ont été distribués qu’en Géorgie, dans le sud de la Russie et dans le nord de la Turquie. Ils ont été détectés pour la première fois en 2014 après le début du programme du Pentagone au « Lugar Center ».
L’épidémie de fièvre charbonneuse («Anthrax») en Géorgie et les essais humains de l’OTAN
En 2007, la Géorgie a mis fin à sa politique de vaccination annuelle obligatoire contre la fièvre charbonneuse du bétail. En conséquence, le taux de morbidité de la maladie a atteint son maximum en 2013. La même année, l’OTAN a commencé les essais de vaccins contre l’anthrax chez l’homme au « Lugar Center » en Géorgie.
Recherche du Pentagone sur l’anthrax russe
L’anthrax est l’un des bio-agents transformé en arme de guerre par l’armée américaine dans le passé. Malgré les affirmations du Pentagone selon lesquelles son programme n’est que défensif, il existe des faits contraires. En 2016, au « Lugar Center », des scientifiques américains ont effectué des recherches sur la « Séquence du génome de la souche 55-VNIIViM du vaccin Bacillus anthracis soviétique et russe », qui a été financée par le « Cooperative Biological Engagement Program » de la « Defense Threat Reduction Agency » (DTRA) des États-Unis à Tbilissi, et administrée par « Metabiota » (l’entrepreneur américain dans le cadre du programme du Pentagone en Géorgie). En 2017, le DTRA a financé d’autres recherches
Dix séquences de génome d’isolats humains et d’animaux de Bacillus anthracis du pays de Géorgie, qui ont été effectuées par l’USAMRU-G au « Lugar Center ».
34 personnes infectées intentionnellement par la fièvre hémorragique de Crimée-Congo (FHCC) en Géorgie. La fièvre hémorragique de Crimée-Congo (FHCC) est causée par une infection par un virus transmis par les tiques (Nairovirus). La maladie a été caractérisée pour la première fois en Crimée en 1944 et a reçu le nom de fièvre hémorragique de Crimée. Elle a ensuite été reconnue en 1969 comme la cause de la maladie au Congo, d’où le nom actuel de la maladie. En 2014, 34 personnes (dont un enfant de 4 ans) ont été infectées par la FHCC dont 3 sont morts. La même année, des biologistes du Pentagone ont étudié le virus en Géorgie dans le cadre du projet DTRA « Epidémiologie des maladies fébriles causées par les virus de la dengue et d’autres arbovirus en Géorgie ». Le projet comprenait des tests sur des patients présentant des symptômes de fièvre et la collecte de tiques, en tant que vecteurs possibles de CCHV pour des analyses de laboratoire.
La cause du foyer de la FHCC en Géorgie est encore inconnue. Selon le rapport du Département vétérinaire local, une seule tique de toutes les espèces collectées dans les villages infectés s’est révélée positive pour la maladie. Malgré les affirmations des autorités locales selon lesquelles le virus a été transmis à l’homme à partir d’animaux, tous les échantillons de sang animal étaient également négatifs. L’absence de tiques et d’animaux infectés est inexplicable étant donné la forte augmentation des cas humains de la FHCC en 2014, ce qui signifie que le foyer n’était pas naturel et que le virus s’est propagé intentionnellement. En 2016, 21 590 autres tiques ont été collectées pour la base de données ADN pour des études futures au Lugar Center dans le cadre du projet du Pentagone « Assessing the Seroprevalence and Genetic Diversity of Crimean-Congo Hemorrhagic Fever Virus (CCHFV) and Hantavirus in Georgia » (Évaluation de la séro prévalence et de la diversité génétique du virus de la fièvre hémorragique de Crimée-Congo) et des virus de l’hantavirus en Géorgie.
Un bio-laboratoire militaire blâmé pour l’épidémie mortelle de la FHCC en Afghanistan
237 cas de fièvre hémorragique de Crimée-Congo (FHCC) ont également été signalés dans tout l’Afghanistan, dont 41 étaient mortels en décembre 2017. Selon le ministère afghan de la Santé, la plupart des cas ont été enregistrés dans la capitale Kaboul, où 71 cas ont été signalés avec 13 morts, et dans la province de Herat, près de la frontière avec l’Iran (67 cas).

L’Afghanistan est l’un des 25 pays du monde avec des laboratoires biologiques du Pentagone sur leur territoire. Le projet en Afghanistan fait partie du programme de bio défense des États-Unis – « Cooperative Biological Engagement Program» (CBEP), financé par la « Defense Threat Reduction Agency » (DTRA). Les entrepreneurs de DTRA, travaillant au « Lugar Center » en Géorgie, « CH2M Hill » et « Battelle » ont également été engagés pour le programme en Afghanistan. « CH2M Hill » a obtenu un contrat de 10,4 millions de dollars (2013-2017). Les entrepreneurs du Pentagone en Afghanistan et en Géorgie sont les mêmes, tout comme les maladies qui se propagent parmi la population locale dans les deux pays.
Pourquoi le Pentagone collectionne et étudie les chauves-souris
Les chauves-souris seraient les hôtes réservoirs du virus Ebola, du syndrome respiratoire du Moyen-Orient (MERS) et d’autres maladies mortelles. Cependant, les modes précis de transmission de ces virus à l’homme sont actuellement inconnus. De nombreuses études ont été réalisées dans le cadre du DTRA « Cooperative Biological Engagement Program » (CBEP) à la recherche d’agents pathogènes mortels d’importance militaire chez les chauves-souris.
L’ingénierie des virus mortels est légale aux États-Unis.
On pense que MERS-CoV provient des chauves-souris et se propage directement aux humains et/ou aux chameaux. Cependant, comme Ebola, les modes précis de propagation du virus sont inconnus. 1980 cas avec 699 décès ont été signalés dans 15 pays à travers le monde (en juin 2017) causés par le MERS-CoV.3.
Tularemia en tant qu’arme biologique
La tularémie, également connue sous le nom de fièvre du lapin, est classée comme un agent bioterroriste et a été développée dans le passé comme tel par les États-Unis. Cependant, les recherches du Pentagone sur la tularémie se poursuivent, ainsi que sur les vecteurs possibles des bactéries telles que les tiques et les rongeurs qui causent la maladie. Le DTRA a lancé un certain nombre de projets sur la tularémie ainsi que d’autres pathogènes particulièrement dangereux en Géorgie. Les agents pathogènes dangereux (EDP), ou agents sélectionnés, représentent une préoccupation majeure pour la santé publique à l’échelle mondiale. Ces agents hautement pathogènes ont le potentiel de devenir des armes avec la preuve de leur importance militaire vue à travers les projets suivants du Pentagone : Épidémiologie et écologie de la tularémie en Géorgie (2013-2016) (60.000 vecteurs ont été collectés pour les isolats de souches et la recherche génomique) ; Épidémiologie de la tularémie humaine en Géorgie et Épidémiologie des maladies humaines et surveillance des pathogènes particulièrement dangereux en Géorgie (étude de certains agents parmi les patients atteints de fièvre indifférenciée et de fièvre hémorragique/choc septique).

Le programme militaire américain est une information sensible.
L’Ukraine n’a aucun contrôle sur les bio laboratoires militaires sur son propre territoire. Conformément à l’accord de 2005 entre le DoD américain et le ministère ukrainien de la santé, le gouvernement ukrainien n’est pas autorisé à divulguer publiquement des informations sensibles sur le programme américain et l’Ukraine est obligée de transférer au ministère américain de la défense (DoD) des pathogènes dangereux pour la recherche biologique. Le Pentagone s’est vu accorder l’accès à certains secrets d’État de l’Ukraine en relation avec les projets dans le cadre de leur accord.
Scientifiques spécialistes de la guerre biologique sous couverture diplomatique
Parmi l’ensemble des accords bilatéraux entre les États-Unis et l’Ukraine figure la création du Science and Technology Center in Ukraine (STCU) – une organisation internationale financée principalement par le gouvernement des États-Unis, à laquelle le statut diplomatique a été accordé. Le STCU soutient officiellement les projets de scientifiques qui participaient auparavant au programme soviétique d’armes biologiques. Au cours des 20 dernières années, le STCU a investi plus de 285 millions de dollars dans le financement et la gestion de quelque 1.850 projets de scientifiques qui travaillaient auparavant à la mise au point d’armes de destruction massive.
364 Ukrainiens sont morts de la grippe porcine
L’un des laboratoires du Pentagone est situé à Kharkiv, où, en janvier 2016, au moins 20 soldats ukrainiens sont morts du virus grippal en seulement deux jours et 200 autres ont été hospitalisés. Le gouvernement ukrainien n’a pas rendu compte des soldats ukrainiens morts à Kharkiv. En mars 2016, 364 décès ont été signalés en Ukraine (81,3 % causés par la grippe porcine A (H1N1) pdm09 – la même souche qui a causé la pandémie mondiale en 2009).
La police enquête sur une infection par une maladie incurable
Une infection à l’hépatite A très suspecte s’est propagée rapidement en quelques mois seulement dans le sud-est de l’Ukraine, où se trouvent la plupart des bio labs du Pentagone. La police locale a lancé une enquête sur « l’infection par le virus de l’immunodéficience humaine et d’autres maladies incurables ». Il y a quatre ans, plus de 100 personnes de la même ville ont été infectées par le choléra. Les deux maladies se seraient propagées par l’eau potable contaminée. Au cours de l’été 2017, 60 personnes atteintes d’hépatite A ont été admises à l’hôpital de la ville de Zaporizhia, la cause de cette épidémie est encore inconnue. Dans la région d’Odessa, 19 enfants d’un orphelinat ont été hospitalisés pour l’hépatite A en juin 2017. 29 cas d’hépatite A ont été signalés à Kharkiv en novembre 2017. Le virus a été isolé dans de l’eau potable contaminée. L’un des laboratoires biologiques du Pentagone est situé à Kharkiv, qui a été blâmé pour l’épidémie mortelle de grippe il y a un an, qui a coûté la vie à 364 Ukrainiens.

L’Ukraine et la Russie frappées par une nouvelle infection au choléra hautement virulente
En 2011, l’Ukraine a été frappée par une épidémie de choléra. 33 patients auraient été hospitalisés pour diarrhée grave. Une deuxième flambée a frappé le pays en 2014, lorsque plus de 800 personnes dans toute l’Ukraine ont été signalées comme ayant contracté la maladie. En 2015, au moins 100 nouveaux cas ont été enregistrés dans la seule ville de Mykolaiv.
Une nouvelle variante très virulente de l’agent du choléra, Vibrio cholera, avec une forte similitude génétique avec les souches signalées en Ukraine, a frappé Moscou en 2014. Selon une étude génétique de l’Institut russe de recherche anti-peste de 2014, la souche de choléra isolée à Moscou était similaire à la bactérie qui a causé l’épidémie en Ukraine voisine. « Southern Research Institute », l’un des entrepreneurs américains travaillant dans les bio-laboratoires en Ukraine, a des projets sur le choléra, ainsi que sur la grippe et Zika – tous des pathogènes d’importance militaire pour le Pentagone. En plus du « Southern Research Institute », deux autres sociétés privées américaines exploitent des bio-laboratoires militaires en Ukraine – « Black&Veatch » et « Metabiota ».
« Black&Veatch Special Project Corp. » a obtenu 198,7 millions de dollars pour la construction et l’exploitation de bio-laboratoires en Ukraine (deux contrats de 5 ans en 2008 et 2012 totalisant 128,5 millions de dollars), ainsi qu’en Allemagne, Azerbaïdjan, Cameroun, Thaïlande, Ethiopie, Vietnam et Arménie. Metabiota a obtenu un contrat fédéral de 18,4 millions de dollars dans le cadre du programme en Géorgie et en Ukraine. Cette société américaine a également été engagée pour effectuer des travaux pour le DTRA avant et pendant la crise d’Ebola en Afrique de l’Ouest, la société a reçu 3,1 millions de dollars (2012-2015) pour des travaux en Sierra Leone. Southern Research Institute est un sous-traitant principal dans le cadre du programme DTRA en Ukraine depuis 2008. La société a également été un entrepreneur principal du Pentagone dans le passé dans le cadre du programme américain des armes biologiques pour la recherche et le développement d’agents biologiques, avec 16 contrats entre 1951 et 1962.
Le Défecteur soviétique a produit de l’anthrax pour le Pentagone
Le « Southern Research Institute » a également été sous-traitant d’un programme du Pentagone pour la recherche sur l’anthrax en 2001. L’entrepreneur principal étant « Advanced Biosystems », dont le président à l’époque était Ken Alibek (un ancien microbiologiste soviétique et expert en guerre biologique du Kazakhstan qui a fait défection aux États-Unis en 1992).
250.000 $ pour le lobbying Jeff Sessions pour la « recherche pour le renseignement américain »

Le « Southern Research Institute » a fait pression sur le Congrès américain et le Département d’État américain pour « des questions liées à la recherche et au développement pour le renseignement américain » et « la recherche et le développement dans le domaine de la défense ». Les activités de lobbying ont coïncidé avec le début des projets du Pentagone sur les bio-laboratoires en Ukraine et dans d’autres anciens États soviétiques. L’entreprise a payé 250.000 $ pour faire du lobbying auprès du sénateur Jeff Sessions en 2008-2009 (actuellement le procureur général américain nommé par Donald Trump), lorsque l’institut s’est vu attribuer un certain nombre de contrats fédéraux.
Pendant une période de 10 ans (2006-2016), le « Southern Research Institute » a payé 1,28 million de dollars pour faire du lobbying auprès du Sénat américain, de la Chambre des représentants, du Département d’État et du Département de la défense (DoD). L’aide du sénateur Jeff Sessions au Capitole – Watson Donald, est maintenant directeur principal au « Southern Research Institute ».
Lisez la troisième partie de cet article
yogaesoteric
27 mars 2019
